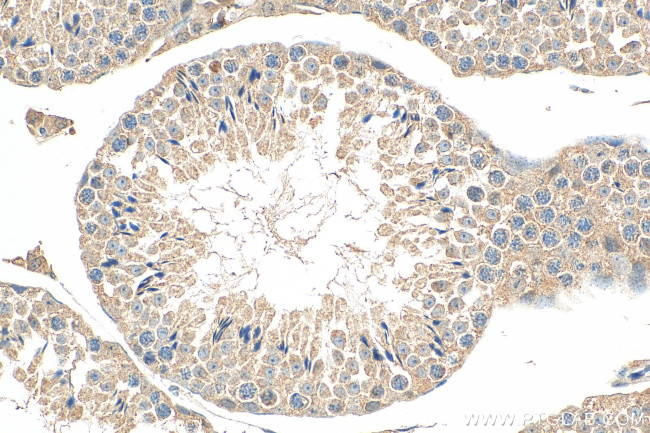
KIAA0182 Antibody in Immunohistochemistry (Paraffin) (IHC (P))

Search
Proteintech
KIAA0182 Polyclonal Antibody
{{$productOrderCtrl.translations['antibody.pdp.commerceCard.promotion.promotions']}}
{{$productOrderCtrl.translations['antibody.pdp.commerceCard.promotion.viewpromo']}}
{{$productOrderCtrl.translations['antibody.pdp.commerceCard.promotion.promocode']}}: {{promo.promoCode}} {{promo.promoTitle}} {{promo.promoDescription}}. {{$productOrderCtrl.translations['antibody.pdp.commerceCard.promotion.learnmore']}}
产品信息
24947-1-AP
种属反应
已发表种属
宿主/亚型
分类
类型
抗原
偶联物
形式
浓度
规格
纯化类型
保存液
内含物
保存条件
运输条件
产品详细信息
Immunogen sequence: TQQQKEELV AQKRRKRRRM LRERSPSPPT IQSKRQTPSP RLALSTRYSP DEMNNSPNFE EKKKFLTIFN LTHISAEKRK DKERLVEMLR AMKQKALSAA VADSLTNSPR DSPAVSLSEP ATQQASLDVE KPVGAAASLS DIPKAAEPGK LEQVRPQELS RVQELAPASG EKARLSEAPG GKKSLSMLHY IRGAAPKDIP VPLSHSTNGK SKPWEPFVAE EFAHQFHESV LQSTQKALQK HKGSVAVLSA EQNHKVDTSV HYNIPELQSS SRAPPPQHNG QQEPPTARKG PPTQELDRDS EEEEEEDDED GEDEEEVPKR KWQGIEAVFE AYQEHIEEQN LERQVLQTQC RRLEARHYSL SLTAEQLSHS VAELRSQKQK MVSERERLQA ELDHLRKCLA LPAMHWPRGY LKGYPR (868-1217 aa encoded by BC037556 )
靶标信息
This gene encodes a proline-rich protein with coiled coil domains that may be a subunit of a BRAF35-HDAC (BHC) histone deacetylase complex. This gene may function as an oncogene in breast cancer and enhanced expression of the encoded protein has been observed in breast cancer patients.
仅用于科研。不用于诊断过程。未经明确授权不得转售。
生物信息学
蛋白别名: CTC-786C10.1; Genetic suppressor element 1; Gse1 coiled-coil protein homolog; KIAA0182; unnamed protein product
基因别名: 2210013I18Rik; CRHSP24; GSE1; KIAA0182; mKIAA0182
UniProt ID: (Human) Q14687, (Mouse) Q3U3C9
Entrez Gene ID: (Human) 23199, (Mouse) 382034